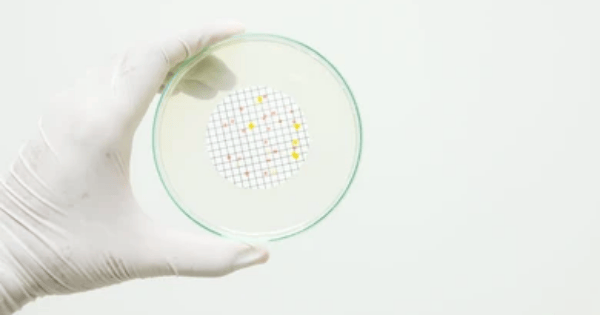

The Silent Revolution in Construction—Powered by EG TECH’s Formwork Solutions
The future of construction is already here, and it’s being shaped by companies like EG TECH System Sdn Bhd. While cranes and concrete steal the

The future of construction is already here, and it’s being shaped by companies like EG TECH System Sdn Bhd. While cranes and concrete steal the

In today’s fast-paced construction environment, time, cost, and sustainability are no longer optional—they’re essential. That’s where EG TECH System Sdn Bhd comes in, offering high-performance

The construction world is constantly evolving—and one of the smartest shifts in recent years is the rise of aluminum formwork systems. Among the key players

In the pharmaceutical manufacturing industry, guaranteeing product safety and regulatory compliance is critical. Microbial contamination poses a substantial risk to product quality and patient safety.

Respirator fit testing is an important aspect of workplace safety since it has a direct impact on employee health and safety. GVS Malaysia’s focus to

Respirators are essential safety devices in places where air quality cannot be managed by other means. GVS Malaysia focusses on supplying high-quality respirators while also
In terms of air purification, technological advancements in bacterial filtration have represented a key milestone in improving public health and safety. GVS Malaysia, an industry

In today’s health-conscious environment, maintaining optimal air quality is critical, and bacterial filters play an important part in doing so. At GVS Malaysia, we understand

Choosing the appropriate syringe filter is critical for obtaining consistent and accurate results in research applications. GVS Malaysia provides a comprehensive range of syringe filters

Syringe filters are essential instruments for sample preparation and purification in both laboratories and industries. However, customers may encounter a number of frequent challenges that
First patent for ‘Infusion device with air intake’ registered by GVS
Discover how EG TECH System Sdn Bhd can support your next construction project with our advanced aluminum formwork solutions. Contact us today to learn more about our products and services, or request a consultation with our expert team.
EG Tech System Sdn Bhd (1511216-P)
© 2025 EG Tech System. All rights reserved.
We are always here for you! send us a mail now if you have any questions!